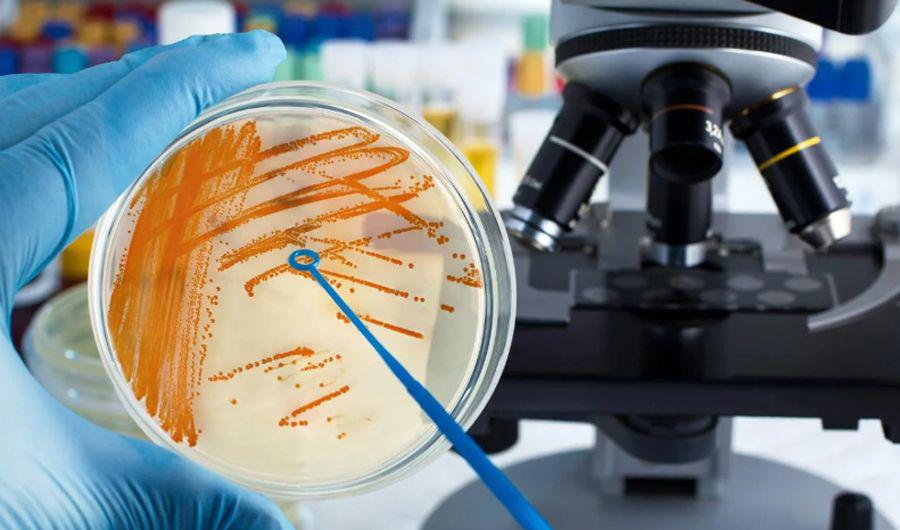
Estreptococo- cuaacutel es el origen de la bacteria

Estreptococo: cuál es el origen de la bacteria Estreptococo: cuál es el origen de la bacteria
El streptococcus pyogenes es una bacteria que produce habitualmente las infecciones de garganta (faringitis) e infecciones en la piel, y es poco frecuente que se presenten infecciones severas como la de los casos de los cinco chicos del Hospital Elizalde. Se trata de un germen para el que no hay vacuna.
De los tres casos no fallecidos, un paciente se encuentra con alta hospitalaria y dos persisten en sala de internación de clínica pediatrica.
El pediatra otorrinolaringólogo Enrique Mansilla (MN 26.379) explicó a CONBIENESTAR que el germen del estreptococo es "benigno", pero cuando raramente transforma su genética "se convierte en uno terriblemente agresivo". Destacó sin embargo, que esto "ocurre en muy pocos casos".
Este germen si bien es más frecuente en esta época del año, las causas de su detección en un número inusual, con cuadro severo, y en tan breve periodo de tiempo se encuentra aún en investigación ya que no es habitual.